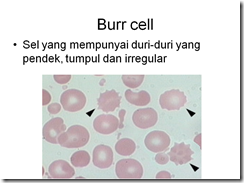

Google Translate
Search
Labels
Anatomi
(13)
Asas Sains Gunaan
(4)
Biokimia
(28)
Biostatistik
(6)
Diagnostik Hematologi
(60)
English
(2)
Imunohematologi
(38)
Kenal Faham Komputer
(2)
Mikrobiologi
(37)
Parasitologi
(42)
Patologi
(5)
Pengajian Islam
(2)
Pengajian Malaysia
(5)
Pengenalan Teknologi Makmal Perubatan
(5)
Sitologi
(16)
Sosiologi
(1)
Teknik histologi
(7)
Popular Posts
Followers
Kunjungan
Traffic Feed
Koleksi
-
▼
2013
(111)
-
▼
March
(66)
- Urinalisis
- Media agar
- RENJATAN DAN EDEMA
- PENGENALAN KEPADA PARASIT MALARIA
- MORFOLOGI P. falciparum, P. vivax, P. malariae, & ...
- JENIS – JENIS UJIAN ASAS BIOKIMIA
- Teknik Ujian Penyaringan Antibodi Hemolisin
- JENIS-JENIS PEWARNAAN
- SISTEM KARDIOVASKULAR
- Penwarnaan Leishman
- METHAMPHETAMINE (SYABU)
- HIPERGLISEMIA
- Ancylostoma ceylanium ( Hookworm )
- MULTI-CHANNEL
- Penganalisaan enzim Alkaline phosphatase (ALP) dal...
- PENGALISIAN SAMPEL FESES SECARA MAKROKOPIK
- SEL EPITELIUM & BUKAN EPITELIUM
- UJIAN-UJIAN PENYARINGAN
- UJIAN SEROLOGI ( TEKNIK IMUNOFLUORESEN )
- Ujian kerapuhan osmosis ( Osmotic Fragility Test )...
- Ujian Denaturasi Alkali
- Ujian Anti-Human Globulin ( Ujian Coomb ).
- UJIAN COOMB’S CONTROL (CCC)
- Ujian Du
- PERJUANGAN KEMERDEKAAN
- Myasthenia gravis (MG) dengan Plasmapheresis
- Penaksiran Aras Kreatinin Dalam Urin
- Menaksir Kolesterol Bebas dalam Darah.
- Menaksir Aras Glukosa Darah.
- Tekanan Darah
- Penyediaan Hemolysate.
- Pembilang Sel Platlet.
- Mengkaji Peralatan Pembilang SDM, SDP, dan Platlet.
- JAUNDIS
- JADUAL BERKALA MODEN
- Coombs test
- Pungutan Dan Pemprosesan Contoh Darah.
- PROSES HEMATOPOEISIS
- JENIS-JENIS DARAH
- KUMPULAN DARAH SCIANNA
- KUMPULAN DARAH KIDD
- KUMPULAN ABO DAN RHESUS (TEKNIK TIDAK LANGSUNG)
- Kumpulan ABO dan RHESUS (TEKNIK LANGSUNG)
- KETAKNORMALAN PEREDARAN DARAH
- LEUKEMIA KRONIK
- LEUKEMIA AKUT
- LEUKEMIA
- KONSEP ASAS LEUKEMIA
- DIAGNOSIS LEUKEMIA MIELOID KRONIK MENGGUNAKAN KAED...
- Apa itu Leukemia?
- ANEMIA PENYAKIT KRONIK
- ANEMIA KEKEKURANGAN FERUM (IRON DEFICIENCY ANAEMIA )
- KRITERIA PENDERMA YANG SESUAI DAN SIHAT
- KRITERIA MENDERMA DARAH
- Dewan Rakyat dan Dewan Negara
- THALASSEMIA
- WESTER BLOT IMMUNOASSAY & PCR ( POLYMERASE CHAIN R...
- Virus Measles ( Campak )
- Keselamatan Makmal dan Kewaspadaan Universal.
- KESELAMATAN DAN PERALATAN MAKMAL
- ALAT RADAS DI DALAM MAKMAL BIOKIMIA
- KAJIAN KES HEPATITIS A
- KAJIAN KES MENGENAI Clostridium Perfringens YANG M...
- KAJIAN KES PENYAKIT CHAGAS
- HEMOLYTIC DISEASES OF NEWBORN ( HDN )
- ABNORMALITI MORFOLOGI SEL DARAH MERAH
-
▼
March
(66)
koleksitugasan.blogspot.com